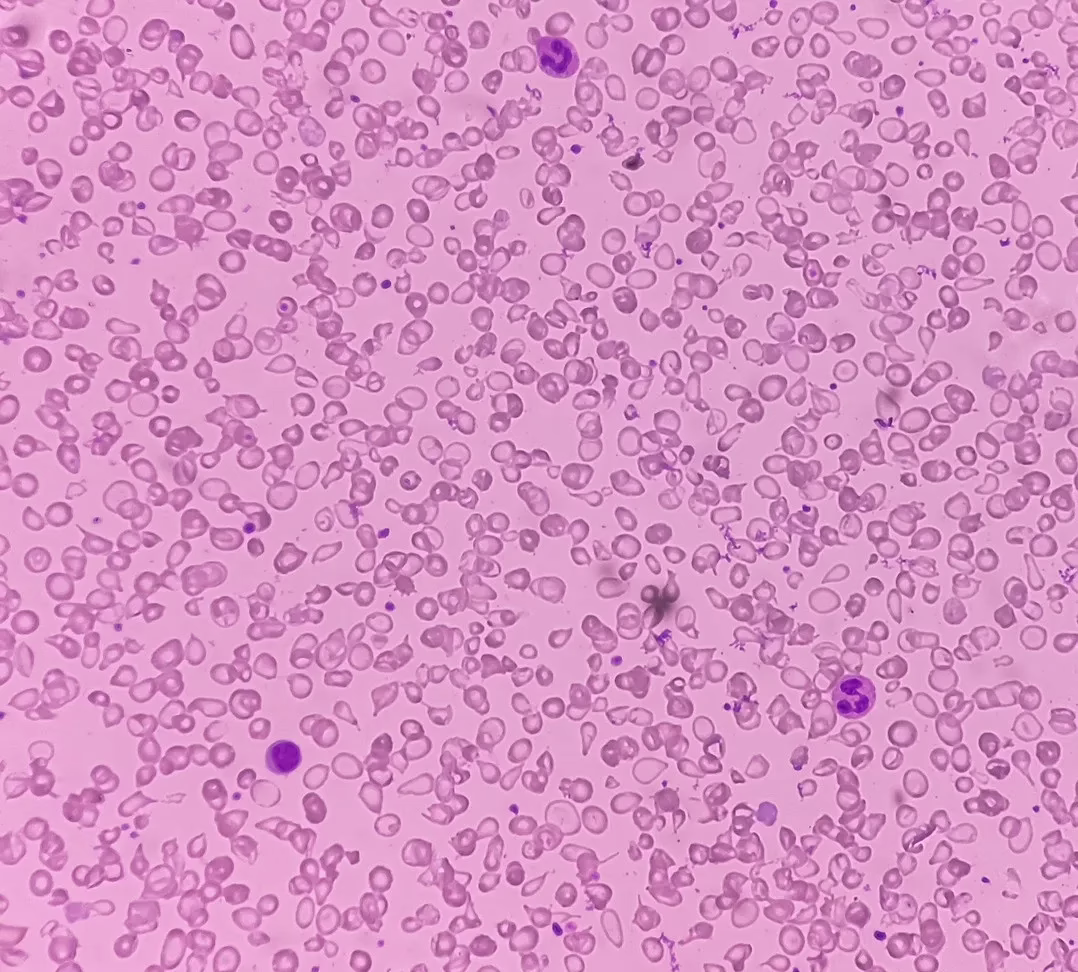

What is FOXO4-DRI?
FOXO4-DRI, also known as Proxofim is a synthetic peptide developed by Dutch research teams. It contains a specific peptide antagonist named FOXO4-DRI. It is a modified protein type designed to trigger the selective death of aged cells. The discovery of this peptide analog has accentuated the attempts for cell aging reversal. Data suggests promising results during its initial testing in mice. FOXO4-DRI peptide bears the potential to promote cell longevity, possibly reduce physiological impacts linked to the onset of dementia, and suppress tumor development.
How does it work?
Cellular biologists have suggested that cells exhaust after 70 divisions and can no longer produce new cells. There does not appear to be any way to induce the continual division of cells without decay. Eliminating aged cells may make space for younger cell development, in a process called autophagy. Damaged cells tend to spread the decay process as well. Aged, decayed cells are considered to be suitable for nothing as they produce no energy. In addition, they keep occupying space within and between cells, hindering the growth of surrounding cells.
FOXO4-DRI peptide appears to work by removing these senescent cells that have outlived their efficacy. Considered to be the most effective senolytic agent to date; the peptide may potentially cease the communication of cells with p53 genes and convey signals that the cell is damaged and needs to be cleared by autophagy. Stem cells are considered to produce new cells after the death and clearance of aged cells. An increase in new cells to replace the aged ones may culminate in better overall physiological functioning.
Research Implications from FOXO4-DRI
Anti-Aging Impacts on Cells
Mitochondria is known as the ‘powerhouse of the cell’ as it is considered to primarily produce energy. The energy currency of an organism is called Adenosine Triphosphate (ATP). The organisms produce it inside the mitochondria due to several complex reactions. Lysosomes are responsible for removing cellular debris, and work as a dustbin of cells to remove aged and dead cells. If any of these structures becomes compromised, physiological functions are considered to decline. Studies found that test mice became healthier as compared to the control group. Mice in the test group achieved better energy levels, biomarkers for physiological function such as replenishment of follicle development, improved kidney function, and cell cycling with this protein.
Diabetes Research
FOXO proteins are considered to regulate insulin signaling and insulin-like growth factors (IGF). FOXO proteins may control cell growth, metabolism, and differentiation by acting on IGF. Future research may explore the effects of FOXO proteins in insulin signaling. This action may have correlative impacts on diabetes and its related complications.
Disclaimer: The products mentioned are not intended for human or animal consumption. Research chemicals are intended solely for laboratory experimentation and/or in-vitro testing. Bodily introduction of any sort is strictly prohibited by law. All purchases are limited to licensed researchers and/or qualified professionals. All information shared in this article is for educational purposes only.